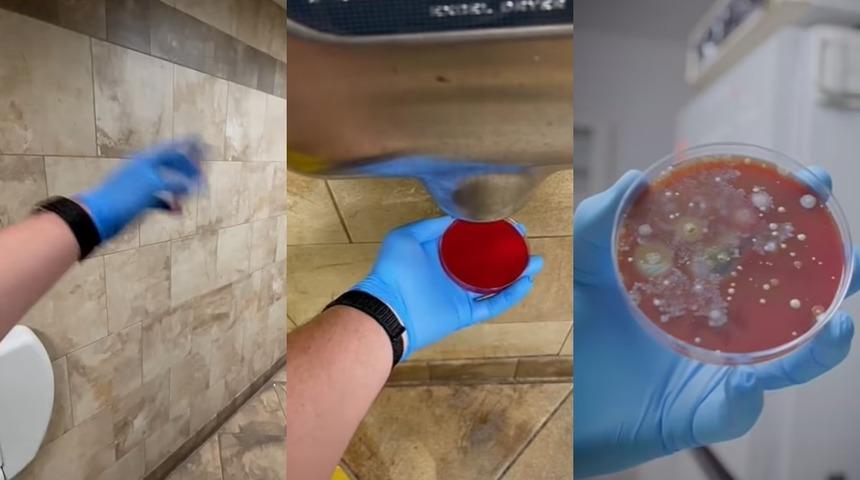
Sonuçlar beklenen çok daha kötü! Her yerdeler: Bir daha asla elinizi uzatmayacaksınız! En iyi yöntem ise...

El kurutma makinelerinin ellerinize bakteri bulaştırıp bulaştırmadığını araştırmak için yola çıkan bir bilim insanı korkunç gerçekleri gün yüzüne çıkardı. ABD Utah’da çeşitli yerlerdeki el kurutma makinelerinden örnek alan 33 yaşındaki Dallin Lewis, bakteri kolonilerinin büyümesine zaman tanımak için onları üç gün boyunca kuluçkaya yatırdı.

Sonuçlar, her tür el kurutma makinesinin altında tutulan petri kaplarında bakteri ve mantarların adeta patlama yaptığını ortaya çıkardı. Elleri kurutmanın en sağlıklı yönteminin elleri havada sallamak olduğunu buldu.

Lewis, el kurutma makineleri için sonuçların beklediğinden 'çok daha kötü' olduğunu söyledi. Sosyal medya hesabından deneyinin aşamalarını anlatan Lewis şunları söyledi:

'Çeşitli yüzeylerde benzer bakteri üreme testleri yaptım. Telefonlar ve benzin pompaları muhtemelen en kötülerinden bazıları ama el kurutma makinesi çok kötüydü!' dedi.
İngiliz bir uzmanın geçtiğimiz gün, tuvalete gittikten sonra ellerinizi kurutmamanın, onları hiç yıkamamaktan daha kötü olabileceği konusunda uyarmasının ardından geldi. 50 yıllık deneyime sahip bir mikrobiyolog olan Dr. David Webber, ellerini düzgün yıkamayan insanların bile sosyal tehditler olarak tanımlanabileceğini söyledi.

Lewis, SWNS'ye verdiği demeçte, test sonuçlarına 'inanılmaz derecede şaşırdığını' söyledi. Kötü olacaklarını biliyordum ama gördüğüm seviyeyi hiçbir şekilde beklemiyordum. Testler ayrıca el kurutma makinelerinin ağızlarında gizli bakteri kolonilerini ortaya çıkardı.
Uzmanlar, ellerinizi yıkadıktan sonra kurutmanın çok önemli olduğunu söylüyor çünkü birçok bakteri türü sıcak ve nemli yerlerde üremeyi seviyor.